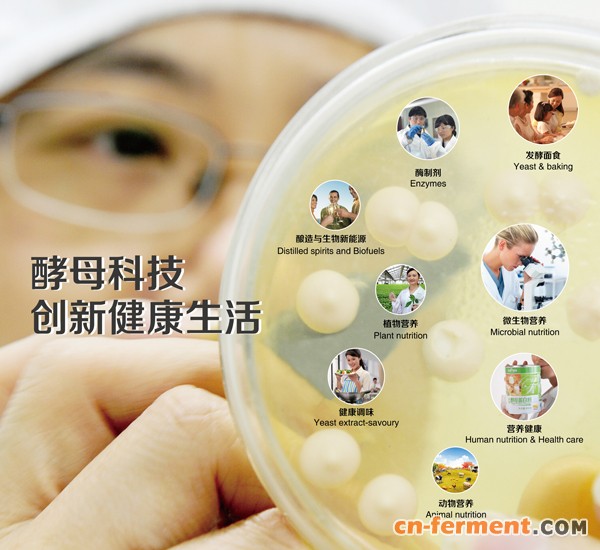

安琪酵母旗下微生物营养事业与营养健康事业联袂参展,以66平米特装展位亮相展会。
安琪以“酵母科技,创新健康生活”为主旨,重点推介了微生物发酵原料、健康食品原料、生物化妆品原料领域、成品培养基产品及博试生生物试剂耗材电商平台等最新研究成果及解决方案,吸引了国内外客商纷纷到展位驻足咨询、洽谈合作。
特别是酵母浸出液干粉、酵母蛋白胨、富硒酵母、酵母葡聚糖等行业领先的创新产品更是吸引了来自全球的知名医药、健康食品及美容护肤品厂商的青睐。

站内搜索
|
新闻中心 安琪 | 微生物营养与营养健康两大业务联袂亮相CPHI展会
发布时间:2017-06-24 浏览次数:402 返回列表
|